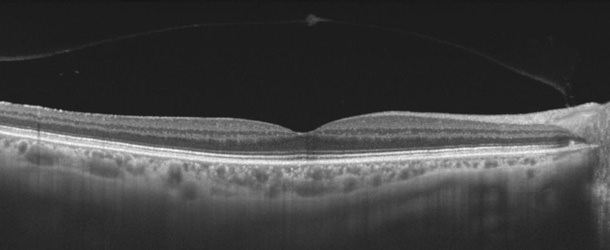

Ninguna, podrá realizar sus actividades antes y después con absoluta normalidad. En algunos casos se preferirá realizar la prueba poniendo gotas para dilatar la pupila para mejorar la calidad de las imágenes.

Ninguna, podrá realizar sus actividades antes y después con absoluta normalidad. En algunos casos se preferirá realizar la prueba poniendo gotas para dilatar la pupila para mejorar la calidad de las imágenes.